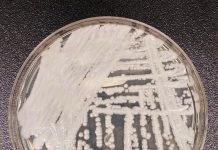

PSAC twierdzi, że osiągnięto wstępne porozumienie w sprawie kontraktu 120 000 urzędników państwowych
Sojusz Służby Publicznej Kanady (PSAC) poinformował, że osiągnął wstępne porozumienie kontraktowe z Radą Skarbu obejmujące ponad 120 000 pracowników rządu federalnego w całym kraju.
Strajk ...
Czy czeka nas rewolucja w rozliczaniu podatku dochodowego?
Ottawa chce automatycznie wypełniać i wysyłać rozliczenia podatkowe najsłabiej zarabiających Kanadyjczyków. Możliwe, że taki system będzie w przyszłości rozszerzony na wszystkich podatników.
W poniedziałek upływa...
Dzieci do 12 roku życia będą jeździć MiWay za darmo
W ramach najnowszego projektu pilotażowego Mississaugi, od 1 maja najmłodsi mieszkańcy miasta przez rok będą mogli jeździć komunikacją miejską za darmo. Zwolnione z opłaty...
Metrolinx: Budowa Eglinton Crosstown West Extension w Mississaudze nie będzie opóźniona
Metrolinx zapewnia, że budowa kolei LRT we wschodniej Mississaudze – Eglinton Crosstown West Extension (ECWE) – nie będzie opóźniona mimo problemów i opóźnień z...
Niagara College przyznało stypendia studentom z Ukrainy
Czworo zagranicznych studentów Niagara College z Ukrainy dostało stypendia w wysokości 10 00 dolarow, co pozwoli im kontynuować naukę. Stypenidia przyznano w ramach inicjatywy...
Ontario uczci koronację króla Karola
Ontario uczci koronację nowego króla uroczystością i bezpłatnym wstępem do wybranych 10 atrakcji turystycznych. Przed legislaturą pojawi się wesołe miasteczko, zostanie oddana salwa honorowa...
Sukcesy polskich kolarzy na torze w Milton
W ubiegły weekend na torze kolarskim w Milton mieliśmy po raz kolejny okazję obejrzeć zawody z serii Pucharu Świata w kolarstwie torowym. Impreza ta...
Ottawa przyznaje sobie nadzwyczajne uprawnienia, aby przygotować się na potencjalne paniki bankowe
Obawy o stan banków w Stanach Zjednoczonych i Szwajcarii skłoniły rząd federalny do przyznania sobie nadzwyczajnych uprawnień w celu powstrzymania wszelkiej paniki finansowej w...
Strajkujący pracownicy federalni blokowali największą kanadyjską bazę wojskową
Dowódca bazy wojskowej wydał ostrzeżenie jednemu z największych członków Sojuszu Służby Publicznej Kanady (PSAC), aby natychmiast zaprzestał wszelkich działań związanych z blokadą bazy lub...
Śmiertelny grzyb Candida auris atakuje
Centrum Kontroli i Prewencji Chorób (CDC) wydało ostrzeżenie przed lekoopornym szczepem grzyba Candida auris (C. auris), rozprzestrzeniającym się w placówkach służby zdrowia w Stanach...